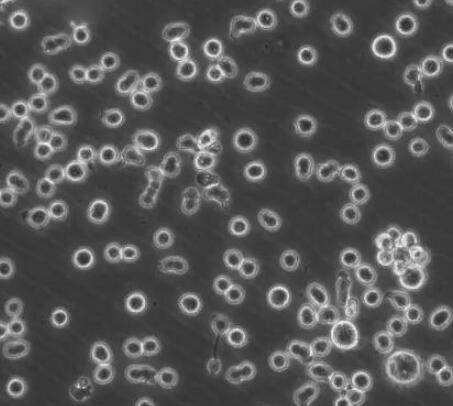
大鼠胸腺淋巴细胞

大鼠胸腺淋巴细胞
Thymic lymphocytes of rats
¥2680
1株
起订
上海 更新日期:2026-04-17
产品详情:
- 中文名称:
- 大鼠胸腺淋巴细胞
- 英文名称:
- Thymic lymphocytes of rats
- 品牌:
- HZBIO/沪震实业
- 产地:
- 上海
- 产品类别:
- 细胞生物学 原代细胞
- 货号:
- HZR-5143
- 规格:
- 5×10⁵Cells/T25培养瓶
- 培养条件:
- 气相:空气,95%;CO2,5%
- 生长特性:
- 悬浮
- 细胞形态:
- 圆形
- 种属:
- 大鼠
公司简介
上海沪震实业有限公司是一家集研发、生产和销售于一体的生命科学实验室产品生物科技企业。主营产品:试剂盒,ELISA试剂盒,抗体,重组蛋白,血清,胎牛血清,细胞,原代细胞 细胞培养试剂,常用生化试剂。
| 成立日期 | (12年) |
| 注册资本 | 100万元整 |
| 员工人数 | 10-50人 |
| 年营业额 | ¥ 100万以内 |
| 经营模式 | 工厂,试剂,定制,服务 |
| 主营行业 | 生化试剂,细胞培养,蛋白组学,分子生物学,细胞生物学 |
大鼠胸腺淋巴细胞相关厂家报价
-

- 大鼠胸腺淋巴原代细胞
- 上海雅吉生物科技有限公司 VIP
- 2026-04-18
- ¥3800
-

- 小鼠胸腺淋巴细胞
- 上海博尔森生物科技有限公司 VIP
- 2026-04-17
- ¥2961
-

- 大鼠胸腺细胞
- 上海康朗生物科技有限公司 VIP
- 2026-04-17
- ¥4050
-

- 大鼠胸腺淋巴细胞
- 上海博尔森生物科技有限公司 VIP
- 2026-04-17
- ¥2961
-

- 大鼠胸腺淋巴细胞
- 青旗(上海)生物技术发展有限公司 VIP
- 2025-09-02
- ¥100